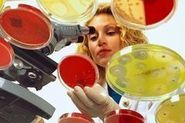

Уровни инфекционной и паразитарной заболеваемости (18 неделя)
Уровни инфекционной и паразитарной заболеваемости по предварительному диагнозу на территории г. Брянск, ее темпах прироста и снижения
|
Заболевания |
Неделя: 20.04.-26.04.15 г. |
Неделя: 27.04.-30.04.15 г. |
рост, снижение |
|
Сумма ОКИ |
47 |
35 |
- 1.34 |
|
ОКИ, неясной этиологии |
46 |
34 |
- 1.35 |
|
Дизентерия |
0 |
0 |
0.00 |
|
ОКИ, установл.этиологии |
0 |
0 |
0.00 |
|
Сальмонеллез |
0 |
1 |
1.00 |
|
Ботулизм |
1 |
0 |
- 1.00 |
|
Ост.вирусный гепатит |
0 |
0 |
0.00 |
|
Носительство гепатита В |
2 |
0 |
- 2.00 |
|
Носительство гепатита С |
12 |
9 |
- 1.33 |
|
Хронический гепатит |
2 |
0 |
- 2.00 |
|
Скарлатина |
11 |
3 |
- 3.67 |
|
Ветряная оспа |
73 |
47 |
- 1.55 |
|
Укусы |
32 |
34 |
1.06 |
|
Педикулез |
15 |
4 |
- 3.75 |
|
Туберкулез |
7 |
3 |
- 2.33 |
|
Микроспория |
4 |
3 |
- 1.33 |
|
Гельминтозы |
4 |
3 |
- 1.33 |
|
Мононуклеоз |
3 |
0 |
- 3.00 |
|
Пневмония |
16 |
29 |
1.81 |
|
ОРВИ |
2042 |
1311 |
- 1.56 |
|
Абсцесс |
1 |
0 |
- 1.00 |
|
Укусы клещами |
3 |
1 |
- 3.00 |